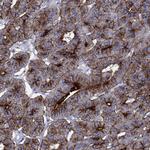
DPP4 Antibody in Immunohistochemistry (Paraffin) (IHC (P))

Search
Invitrogen
DPP4 Polyclonal Antibody
{{$productOrderCtrl.translations['antibody.pdp.commerceCard.promotion.promotions']}}
{{$productOrderCtrl.translations['antibody.pdp.commerceCard.promotion.viewpromo']}}
{{$productOrderCtrl.translations['antibody.pdp.commerceCard.promotion.promocode']}}: {{promo.promoCode}} {{promo.promoTitle}} {{promo.promoDescription}}. {{$productOrderCtrl.translations['antibody.pdp.commerceCard.promotion.learnmore']}}
产品信息
PA5-140252
种属反应
宿主/亚型
分类
类型
抗原
偶联物
形式
浓度
规格
纯化类型
保存液
内含物
保存条件
运输条件
RRID
产品详细信息
Gently mix before use. Optimal concentrations and conditions for each application should be determined by the user.
Immunogen sequence: MDICDYDESS GRWNCLVARQ HIEMSTTGWV GRFRPSEPHF TLDGNSFYKI ISNEEGYRHI CYFQIDKKDC TFITKGTWEV IGIEALTSDY LY
Highest antigen sequence indentity to the following orthologs: Rat - 69%, Mouse - 75%.
靶标信息
CD26 (dipeptidyl peptidase IV, DPP IV), adenosine deaminase (ADA) binding protein) is a homodimeric atypical serine protease belonging to the prolyl oligopeptidase family. CD26 is expressed on lymphocyte cells and is upregulated during T-cell activation. CD26 is also expressed on activated B cells and natural killer cells and abundantly on epithelia. CD26 is implicated in a variety of biological functions including T-cell activation, cell adhesion with extracellular matrix such as fibronectin or collagens, and in HIV infection. CD26 identical to adenosine deaminase complexing protein-2, and to the T-cell activation antigen CD26. Further, CD26 is an intrinsic membrane glycoprotein and a serine exopeptidase that cleaves X-proline dipeptides from the N-terminus of polypeptides. Alterations in CD26 peptidase activity are characteristic of malignant transformation, and the enzymatic activity increases dramatically with tumor grade and severity. CD26 is expressed in various blood cell types, but also in cells that are histogenetically related to activated fibroblasts. Alterations in CD26 density have been reported on circulating monocytes and CD4+ T cells during rheumatoid arthritis and systemic lupus erythematosus.
仅用于科研。不用于诊断过程。未经明确授权不得转售。
篇参考文献 (0)
生物信息学
蛋白别名: ADABP; ADCP-2; Adenosine deaminase complexing protein 2; CD26; Dipeptidyl peptidase 4; Dipeptidyl peptidase IV; dipeptidylpeptidase 4; dipeptidylpeptidase IV (CD26, adenosine deaminase complexing protein 2); DPP IV; DPP-IV; Gly-Pro naphthylamidase; Post-proline dipeptidyl aminopeptidase IV; T-cell activation antigen CD26; TP103; Xaa-Pro-dipeptidylaminopeptidase
基因别名: ADABP; ADCP2; CD26; DPP4; DPPIV; TP103
UniProt ID: (Human) P27487
Entrez Gene ID: (Human) 1803